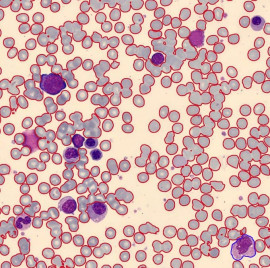

Applications
Lateral Flow Assays (LFA) have been around since the 1980s and are used in most biological and medical fields. During the Covid-19 Pandemic everyone has come into contact with this technology because, most Covid-19-rapid-tests rely on its principle. LFAs are also commonly used in pregnancy tests.
They are also applied in clinical settings. Our partners from the faculty of Medical and Life Sciences at the university of Furtwangen used them for diagnostic and therapeutic purposes: In one project LFAs were developed to detect Sepsis related biomarkers such as interleukin-6 and C-reactive Protein, another one used tests to supervise medication dosages in the treatment of tachycardia.
Principle
LTAs consist of a specifically coated surface through which the test solution flows laterally (hence the name). The results are usually obtained by one of the following two methods.
Sandwich Assays
Sandwich Assays are normally used for larger molecules with multiple binding sides. Flowing along the surface the solution first comes into contact with analyte specific antibodies tagged with signaling particles (often colloidal gold) to which are bound by the analyte.
Next, the solution passes the test line, which consists of antibodies bound to the surface. When the analyte flows over the test line, it is bound by surface antibodies. Since the analyte was tagged with a colorful marker beforehand, the test line becomes visible and the test can be interpreted as positive.
If the analyte is not present, the link between test line-antibody and marker cannot be formed and the test line stays colorless and therefore invisible.
Competive Assay
A Competitive Assay is used for small molecules with only one binding side. As in the previous method, the analyte will be tagged with antibodies with visual markers, but in this case the test line is not made from antibodies but from the analyte itself. Since the markers are already bound to the flowing analyte, they cannot bind to the test line and it stays colorless.
If the analyte is absent in the test solution, the markers will be unbound when arriving at the test line. Therefore, they can bind to the test line, which as a result becomes visible.In other words, an absent test line indicates a positive test.
Most tests also include a control line after the test line, which binds unbound markers. It is used to ensure that the test has worked correctly. Furthermore, its intensity can serve as a reference value when computing analyte concentration.
HSA Lateral Flow Test Analysis Module
In our work we focused on evaluating Lateral Flow Assays in order to derive substrate concentration.
The basis of the analysis are grey value images of several test strips. Since only small parts of the image contain control and test lines a Faster R-CNN Model for object detection was trained to automatically identify these areas.
After finding all areas of interest, a classical image analysis is performed. First dimensionality is reduced by averaging over each row. A grey value graph is obtained with one or two visible peaks. Since the area of these peaks is proportional to the intensity of the control or test line, the integral under both is computed. Substrate concentrations are computed using the relation between both areas.
This concept was implemented and then integrated into our Analysis Kit, enabling automatic processing from importing the images to retrieving numerical results for further research.